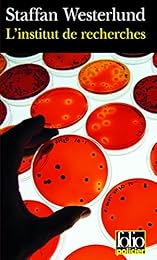
L' institut de recherches

Echange de livres - Policier et Suspense : "Recherches"
Résultats 1-12 sur 12.
-
d'info Recherche cadavre exquis
2016 - Marina Wurtz
Recherche cadavre exquis
2016 - Marina Wurtz
-
d'info À la recherche d'Hemingway
2013 - Leif Davidsen
À la recherche d'Hemingway
2013 - Leif Davidsen
-
d'info Les requins de la recherche
2012 - Daniel Herna...
Les requins de la recherche
2012 - Daniel Herna...
-
d'info À la recherche d'Hemingway
2010 - Leif Davidsen
À la recherche d'Hemingway
2010 - Leif Davidsen
-
d'info À la recherche de Klingsor
2008 - Jorge Volpi ...
À la recherche de Klingsor
2008 - Jorge Volpi ...
-
d'info À la recherche de la cité perdue
2007 - Clive Cussler
À la recherche de la cité perdue
2007 - Clive Cussler
-
d'info L' institut de recherches
2005 - Staffan West...
L' institut de recherches
2005 - Staffan West...
-
d'info À la recherche de Rita Kemper
2004 - Luna Satie
À la recherche de Rita Kemper
2004 - Luna Satie
-
d'info Recherchée
2003 - Karin Alvtegen
Recherchée
2003 - Karin Alvtegen
-
d'info À la recherche de Klingsor
2003 - Jorge Volpi ...
À la recherche de Klingsor
2003 - Jorge Volpi ...
-
d'info À la recherche de Rita Kemper
2002 - Luna Satie
À la recherche de Rita Kemper
2002 - Luna Satie
-
d'info Nymphomane recherche plaisir
2002 - Brigitte Lan...
Nymphomane recherche plaisir
2002 - Brigitte Lan...
